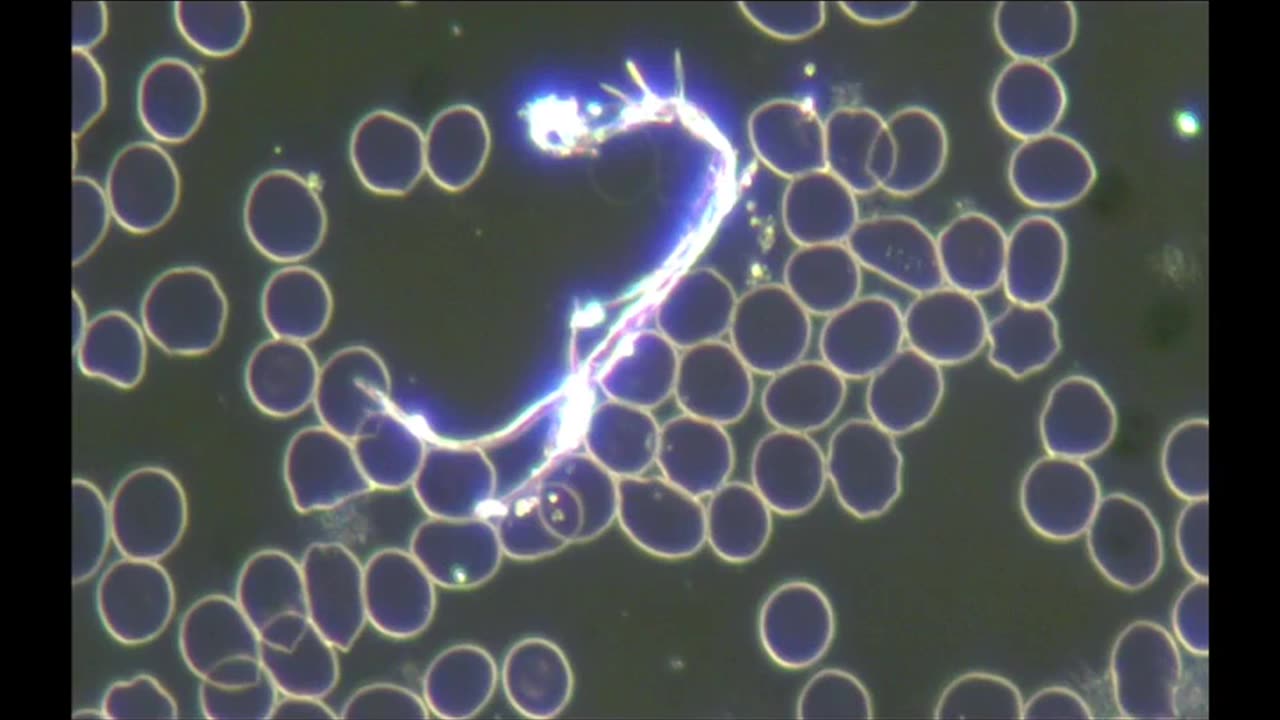

Premium Only Content
This video is only available to Rumble Premium subscribers. Subscribe to
enjoy exclusive content and ad-free viewing.
VACCINE INJURY LIVE BLOOD ANALYSIS
Loading comments...
-
 23:56
23:56
marcushouse
16 hours ago $4.50 earnedStarship Began the Demolition!? 🔥
20.5K5 -
 17:59
17:59
JohnXSantos
1 day agoI Gave AI 14 Days to Build NEW $5K/MONTH Clothing Brand
7.74K3 -
 LIVE
LIVE
DLDAfterDark
6 hours agoGun Talk - Whiskey & Windage - The "Long Range" Jouney - After Hours Armory
257 watching -
 9:37
9:37
Film Threat
8 hours agoSHELBY OAKS REVIEW | Film Threat
7.74K6 -
 35:40
35:40
The Mel K Show
3 hours agoMel K & Dr. Mary Talley Bowden MD | Heroes of the Plandemic: Doing What is Right No Matter the Cost | 10-25-25
18K10 -
 3:06:20
3:06:20
FreshandFit
8 hours agoNetworking At Complex Con With DJ Akademiks
193K22 -
 LIVE
LIVE
SpartakusLIVE
6 hours agoThe King of Content and the Queen of Banter || Duos w/ Sophie
207 watching -
 1:47:12
1:47:12
Akademiks
6 hours agoLive on complexcon
33.7K4 -
 3:07:36
3:07:36
Barry Cunningham
8 hours agoCAN PRESIDENT TRUMP STOP THE STORMS? ON AIR FORCE ONE | SNAP BENEFITS | MAMDANI | SHUTDOWN DAY 25
36.1K36 -
 13:38
13:38
Exploring With Nug
13 hours ago $0.09 earnedWe Searched the Canals of New Orleans… and Found This!
29.2K6